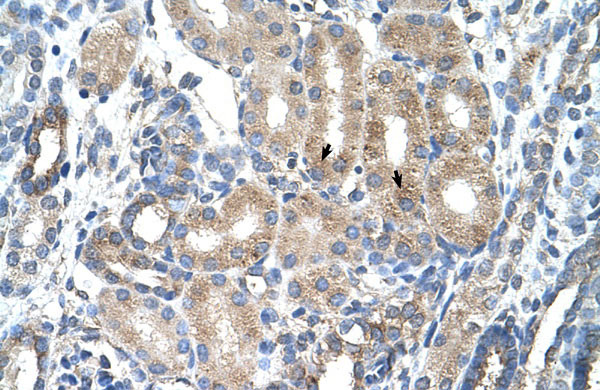
2 - AGER antibody - C-terminal region AI11921

AGER antibody - C-terminal region
Rabbit Polyclonal Antibody
- 产品详情
- 实验流程
Application
| WB, IHC |
|---|---|
| Primary Accession | A2BFI7 |
| Other Accession | NM_172197, NP_751947 |
| Reactivity | Human |
| Predicted | Human |
| Host | Rabbit |
| Clonality | Polyclonal |
| Calculated MW | 38 KDa |
| Alias Symbol | MGC22357, RAGE |
|---|---|
| Format | Liquid. Purified antibody supplied in 1x PBS buffer with 0.09% (w/v) sodium azide and 2% sucrose. |
| Reconstitution & Storage | Add 100 ul of distilled water. Final anti-AGER antibody concentration is 1 mg/ml in PBS buffer with 2% sucrose. For longer periods of storage, store at 20°C. Avoid repeat freeze-thaw cycles. |
| Precautions | AGER antibody - C-terminal region is for research use only and not for use in diagnostic or therapeutic procedures. |
Research Areas
For Research Use Only. Not For Use In Diagnostic Procedures.
Application Protocols
Provided below are standard protocols that you may find useful for product applications.
终于等到您。ABCEPTA(百远生物)抗体产品。
点击下方“我要评价 ”按钮提交您的反馈信息,您的反馈和评价是我们最宝贵的财富之一,
我们将在1-3个工作日内处理您的反馈信息。
如有疑问,联系:0512-88856768 tech-china@abcepta.com.























 癌症的基本特征包括细胞增殖、血管生成、迁移、凋亡逃避机制和细胞永生等。找到癌症发生过程中这些通路的关键标记物和对应的抗体用于检测至关重要。
癌症的基本特征包括细胞增殖、血管生成、迁移、凋亡逃避机制和细胞永生等。找到癌症发生过程中这些通路的关键标记物和对应的抗体用于检测至关重要。 为您推荐一个泛素化位点预测神器——泛素化分析工具,可以为您的蛋白的泛素化位点作出预测和评分。
为您推荐一个泛素化位点预测神器——泛素化分析工具,可以为您的蛋白的泛素化位点作出预测和评分。 细胞自噬受体图形绘图工具为你的蛋白的细胞受体结合位点作出预测和评分,识别结合到自噬通路中的蛋白是非常重要的,便于让我们理解自噬在正常生理、病理过程中的作用,如发育、细胞分化、神经退化性疾病、压力条件下、感染和癌症。
细胞自噬受体图形绘图工具为你的蛋白的细胞受体结合位点作出预测和评分,识别结合到自噬通路中的蛋白是非常重要的,便于让我们理解自噬在正常生理、病理过程中的作用,如发育、细胞分化、神经退化性疾病、压力条件下、感染和癌症。